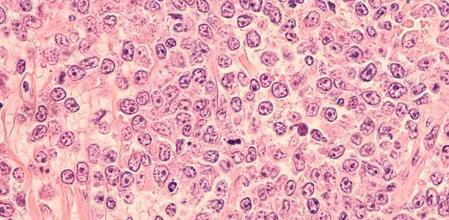
Horizontal

El linfoma no Hodgkin (LNH) o linfoma no hodgkiniano es un término que se utiliza para definir muchos tipos de cáncer que comparten características y que comienzan en un tipo de glóbulos blancos: los linfocitos. El linfoma no Hodgkin se ubica en el sistema linfático compuesto por: la linfa, los vasos linfáticos, los ganglios linfáticos, el bazo, las amígdalas, el timo y la médula ósea.
Suele afectar a adultos, hombres y mujeres aunque es más frecuente en hombres. También se han registrado casos en niños. En España, según datos de la sociedad española de oncología médica, ocupa el noveno puesto en casos de muerte por tumor aunque el porcentaje de mortalidad por este tumor está disminuyendo.
Causas del linfoma no Hodgkin
Desconocidas
No se han definido causas concretas que hayan sido identificadas como responsables de la aparición de un linfoma no Hodgkin excepto que en los casos en que el sistema inmune está debilitado aumenta el número de linfocitos porque los viejos no mueren, continúan creciendo y dividiéndose a pesar de que el organismo no deja de producir linfocitos nuevos.
El excedente lleva a la acumulación de linfocitos en los ganglios linfáticos. Además, se han apuntado varios factores de riesgo de LNH como:
- La edad.
- Es más frecuente en hombres que en mujeres aunque algunos tipos de LNH aparecen más en mujeres.
- Es más común en países desarrollados.
- Antecedentes familiares.
- Obesidad o sobrepeso.
- Exposición a ciertos químicos como el benceno, ciertos herbicidas e insectidas; sin embargo estas asociaciones aún no se han demostrado de forma concluyente.
- Exposición a quimioterapia.
- Exposición a radiación.
- Tener un sistema inmunitario debilitado o una enfermedad autoinmune como la artritis reumatoide.
- Tener infecciones que afecten al ADN de los linfocitos como el VIH.
- Infecciones que mantienen el sistema inmune constantemente activo como la producida por la bacteria Helicobacter pylori.
- Implantes de mama de que tienen superficies ásperas.
Hay varios tipos de linfocitos: los B, T y NK. Los linfocitos B se encargan de producir anticuerpos (inmunoglobulinas); los linfocitos T se producen en la médula ósea y maduran en el timo, una glándula que forma parte del sistema inmune adaptativo; y los linfocitos NK (natural killer) o célula asesina natural tiene como función la destrucción de las células infectadas y/o cancerosas. Según el tipo de linfocitos que haya enfermado se debe incluir en la clasificación del linfoma (linfoma de origen B, linfoma de origen T, linfoma de origen NK).
La clasificación de linfomas no Hodgkin puede ser por:
- Crecimiento lento o indolentes. Pueden ser muy difíciles de curar si están muy extendidos. Algunos tipos son: linfoma de linfocitos pequeños o los linfomas foliculares.
- Crecimiento rápido o agresivos. Son potencialmente mortales si no se tratan de forma precoz. Algunos tipos son: el linfoma de células grandes, el linfoma linfoblástico o el linfoma de Burkitt.
- Si su origen es extranodal, fuera de los ganglios linfáticos, su nombre dependerá de la situación del linfocito que originó el tumor: linfoma cutáneo, linfoma cerebral, linfoma pulmonar, linfoma testicular, linfoma gastrointestinal…
- Si su origen es nodal, en un ganglio linfático, su nombre depende del ganglio.
Síntomas del linfoma no Hodgkin
Muy variados
La sintomatología del linfoma no Hodgkin depende, sobre todo, del tipo concreto pero la mayoría de pacientes presentan:
- Ganglios inflamados palpables (linfadenopateía).
- Fiebre, que puede ser mayor a 38 ºC.
- Pérdida de peso que puede ser superior al 10% del peso corporal.
- Sudoración profusa sin explicación por otras causas.
- Cansancio.
- Falta de apetito.
- Malestar general.
- Picor (prurito).
- Tos.
- Dificultad para respirar.
- Dolor óseo.
- Dolor abdominal.
Diagnóstico del linfoma no Hodgkin
Ganglios linfáticos palpables
El examen físico es fundamental para detectar un linfoma no Hodgkin ya que los ganglios linfáticos palpables se detectan en ese procedimiento. El especialista puede solicitar análisis de sangre y orina; pruebas de imagen con la tomografía computerizada (TC), resonancia magnética (RM) o una tomografía por emisión de positrones (PET). Además, será precisa una biopsia de los ganglios de un mínimo de 1 centímetro. También se puede realizar una punción de aspiración con aguja fina (PAAF).
Si se confirma el diagnóstico el siguiente paso es determinar el estadio: 0, I, II, III o IV.
- El estadio I afecta a una sola región de ganglios linfáticos o a un solo órgano o zona extralinfática.
- El estadio II afecta a dos o más regiones de ganglios linfáticos en el mismo lado del diafragma, un solo órgano o zona extralinfática y sus ganglios linfáticos regionales.
- El estadio III afecta a ganglios linfáticos de ambos lados del diafragma además de incluir afectación de un órgano o zona extralinfática e implicar al bazo.
- Por último, el estadio IV es la afectación diseminada de una o más zonas extralinfáticas con asociación de ganglios linfáticos o sin ella. Con afectación aislada de una zona extralinfática y hay complicación ganglionar no regional o distante. Si se designa la E hay malignidades linfoides extraganglionares en tejidos separados, pero cercanos, de los conglomerados linfáticos principales.
Si el especialista utiliza letras A o B indica que, si es A, no hay síntomas signficativos resultado del cáncer. Si es B hay signos significativos como fiebre persistente y alta, mayor de 38 ºC, adelgazamiento involuntario superior al 10% y sudoraciones nocturnas intensas.
Tratamiento y medicación del linfoma no Hodgkin
Depende del tipo de LNH
Si el tipo de linfoma no Hodgkin es poco activo probablemente se programen revisiones regulares cada pocos meses para controlar la enfermedad y su avance.
Si el linfoma es indolente y está en estadio I y II el oncólogo puede considerar un tratamiento con radioterapia o quimioterapia y radioterapia. En los estadios III y IV se puede variar desde la observación expectante al tratamiento activo con quimioterapia, radioterapia o terapias biológicas con anticuerpos monoclonales (rituximab) o la radioinmunoterapia. En los LNH agresivos el tratamiento se suele basar en quimioterapia y rituximab.
Prevención del linfoma no Hodgkin
Sin prevención
No se han definido unas medidas concretas para prevenir un LNH excepto tratar de evitar los factores de riesgo modificables como la obesidad, la exposición a químicos, limitar el riesgo de exposición a ciertas infecciones y hacer lo posible por mantener un sistema inmune saludable.